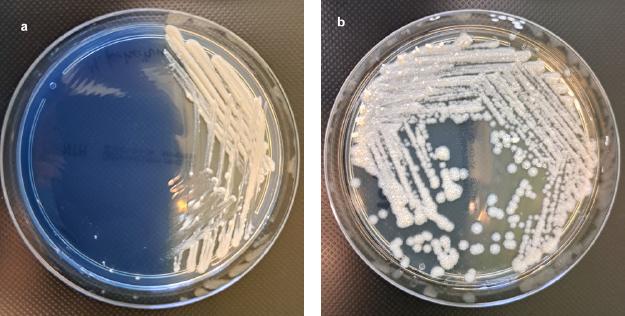
Culture of rapidly growing non-tuberculous mycobacteria on selective NTM Elite agar (bioMérieux, France), after 5 days of incubation at 37°C under aerobic conditions.
a) colonies of Mycobacterium fortuitum subsp. fortuitum ATCC® 6841™, b) rough colonies of Mycobacterium abscessus subsp. abscessus.

Fig. 1.

Fig. 2.

Fig. 3.

Fig. 4.
Fig. 5.

Fig. 6.

Fig. 7.

Results of susceptibility testing to antimycobacterial agents obtained by Sensititre™ RAPMYCO2 plates_ Interpretation criteria following CLSI_
| MIC values (μg/ml) (Interpretation S/I/R) | ||||||||||||
|---|---|---|---|---|---|---|---|---|---|---|---|---|
| No. | Species | AN | FOX | CIP | DOX | LZD | MXF | SXT | IMI | TGC | CLA after 5d | CLA after 14 d |
| 1 | Mabs | 16 (S) | 64 (I) | > 4 (R) | > 16 (R) | ≤ 1 (S) | 4 (R) | 4/76 (R) | 16 (I) | MIC = 1 | 0,06 (S) | 0,125 (S) |
| 2 | Mabs | 16 (S) | >128 (R) | > 4 (R) | > 16 (R) | 4 (S) | 2 (I) | > 8/152 (R) | 16 (I) | MIC = 0,5 | 0,06 (S) | > 16 (R) |
| 3 | Mabs | 16 (S) | 32 (I) | > 4 (R) | > 16 (R) | 4 (S) | > 8 (R) | 4/76 (R) | 16 (I) | MIC = 0,5 | 0,5 (S) | > 16 (R) |
| 4 | Mabs | 16 (S) | >128 (R) | > 4 (R) | > 16 (R) | 16 (I) | > 8 (R) | > 8/152 (R) | 16 (I) | MIC = 2 | 0,06 (S) | > 16 (R) |
| 5 | Mabs | 16 (S) | 64 (I) | > 4 (R) | > 16 (R) | 16 (I) | > 8 (R) | > 8/152 (R) | 16 (I) | MIC = 1 | 0,06 (S) | > 16 (R) |
| 6 | Mabs | 16 (S) | 64 (I) | > 4 (R) | > 16 (R) | 4 (S) | > 8 (R) | > 8/152 (R) | 16 (I) | MIC = 2 | 4 (I) | > 16 (R) |
| 7 | Mmas | - | - | - | - | - | - | - | - | - | - | - |
| 8 | Mmas | 16 (S) | >128 (R) | > 4 (R) | > 16 (R) | 16 (I) | 4 (R) | 4/76 (R) | 16 (I) | MIC = 0,25 | 0,06 (S) | 0,125 (S) |
| 9 | Mabs | 16 (S) | >128 (R) | > 4 (R) | > 16 (R) | 16 (I) | 4 (R) | 4/76 (R) | 16 (I) | MIC = 0,5 | 0,06 (S) | 0,125 (S) |
| 10 | Mmas | 16 (S) | 32 (I) | > 4 (R) | 1 (S) | 1 (S) | 2 (I) | 2/38 (S) | 16 (I) | MIC = 0,5 | 0,06 (S) | 0,06 (S) |
| 11 | Mbol | 4(S) | 32 (I) | > 4 (R) | > 16 (R) | 4 (S) | > 8 (R) | > 8/152 (R) | 16 (I) | MIC = 0.25 | 0.06 (S) | > 16 (R) |
| 12 | Mabs | 4 (S) | 33 (I) | > 4 (R) | > 16 (R) | 8 (S) | > 8 (R) | > 8/152 (R) | 16 (I) | MIC = 0.12 | 4 (I) | > 16 (R) |
Interpretation of susceptibility pattern of rapidly growing mycobacteria according to the CLSI recommendations_
| Antimycobacterial agents | MIC breakpoints (μg/ml) | ||
|---|---|---|---|
| S | I | R | |
| Amikacin | ≤ 16 | 32 | ≥ 64 |
| Cefoxitin | ≤ 16 | 32-64 | ≥ 128 |
| Doxycycline | ≤ 1 | 2-4 | ≥ 32 |
| Ciprofloxacin | ≤ 1 | 2 | ≥ 4 |
| Clarithromycin | ≤ 2 | 4 | ≥ 8 |
| Linezolid | ≤ 8 | 16 | ≥ 32 |
| Moxifloxacin | ≤ 1 | 2 | ≥ 4 |
| Trimthoprim/sulfamethoazole | ≤ 2/38 | – | ≥ 4/76 |
| Imipenem | ≤ 4 | 8-16 | ≥ 32 |
| Tigecycline* | – | – | – |
Results of molecular identification of resistance mechanisms to amikacin obtained by GenoType NTM in relation to phenotypic susceptibility testing results_
| No. of strain | Species | GenoType NTM-DR results | Phenotypic results of susceptibility to amikacin | |
|---|---|---|---|---|
| Type of bands (WT or mutation) | Molecular mechanisms of resistance (Yes/No) | |||
| 1 | Mabs | rrs rrs WT | No | (S) |
| 2 | Mabs | rrs rrs WT | No | (S) |
| 3 | Mabs | rrs rrs WT | No | (S) |
| 4 | Mabs | rrs rrs WT | No | (S) |
| 5 | Mabs | rrs rrs WT | No | (S) |
| 6 | Mabs | rrs rrs WT | No | (S) |
| 7 | Mmas | rrs rrs WT | No | nt |
| 8 | Mmas | rrs rrs WT | No | (S) |
| 9 | Mabs | rrs MUT1 (A1408G) | Yes | (S) |
| 10 | Mmas | rrs rrs WT | No | (S) |
| 11 | Mb ol | rrs rrs WT | No | (S) |
| 12 | Mabs | rrs rrs WT | No | (S) |
j_pjm-2023-048_tab_007
| Strip 1 | – a clinical strain of Mycobacterium abscessus subs. abscessus (band characteristic for M. abscessus subsp. abscessus; SP4, SP5, SP6, SP9, SP10); no point mutation was detected; |
| Strips 2-6, 10, 12 - | –clinical strains of M. abscessus subs. abscessus (band characteristic for M. abscessus subsp. abscessus; SP4, SP5, SP6, SP9, SP10); point mutation erm(41)T28 referring to macrolide resistance; |
| Strips 7, 9 | – clinical strains of M. abscessus subs. massiliense (band characteristic for M. abscessus subsp. massiliense; SP4, SP5, SP8, SP9); point mutation erm(41)T28 no clinical implication in case of M. masiliense; |
| Strips 8 | – clinical strains of M. abscessus subs. abscessus (band characteristic for M. abscessus subsp. abscessus; SP4, SP5, SP6, SP9, SP10); point mutations were detected: erm(41)T28 and rrl MUT referring to macrolide resistance as well as point mutation A1408G referring to amikacin resistance; |
| Strip 11 | – clinical strains of M. abscessus subs. bolletii (band characteristic for M. abscessus subsp. bolletii; SP4, SP5, SP6, SP7, SP9, SP10), point mutation erm(41)T28 referring to macrolide resistance. |
Interpretation of the mutation type conferring to the macrolides and aminoglicosides resistance according to the GenoType NTM-DR VER 1_0 test instructions_
| Discernible phenotypic pattern resistance | Target nucleic acid sequence | Nascent mutation band | Mutation |
|---|---|---|---|
| Macrolides | 2058–2059 | rrl MUT1 | A2058C |
| rrl MUT2 | A2058G | ||
| – | A2058T | ||
| rrl MUT3 | A2059C | ||
| rrl MUT4 | A2059T | ||
| Aminoglycosides | 1406–1409 | rrs MUT1 | A1408G |
| – | T1406A | ||
| – | C1409T |
Results of susceptibility testing to amikacin and clarithromycin obtained by manually conducted microdilution method_ Interpretation criteria following CLSI_
| No. | Species | AN | Interpretation* | CLA after 5 days of incubation | Interpretation* | CLA after 14 days of incubation | Interpretation* |
|---|---|---|---|---|---|---|---|
| 1 | Mabs | 16 | (S) | 0.06 | (S) | 0,5 | (S) |
| 2 | Mabs | 8 | (S) | 0.06 | (S) | > 64 | (R) |
| 3 | Mabs | 16 | (S) | 0.06 | (S) | = 32 | (R) |
| 4 | Mabs | 16 | (S) | 0.06 | (S) | = 32 | (R) |
| 5 | Mabs | 16 | (S) | 0.06 | (S) | = 32 | (R) |
| 6 | Mabs | 16 | (S) | 0.06 | (S) | = 32 | (R) |
| 7 | Mmas | – | – | – | – | – | – |
| 8 | Mmas | 16 | (S) | 0.06 | (S) | = 0.125 | (S) |
| 9 | Mabs | 16 | (S) | 0.06 | (S) | = 0.125 | (S) |
| 10 | Mmas | 16 | (S) | 0.06 | (S) | = 0.06 | (S) |
| 11 | Mbol | 0.5 | (S) | 0.06 | (S) | > 64 | (R) |
| 12 | Mabs | 0.250 | (S) | 4 | (R) | = 16 | (R) |
Results of molecular identification of resistance mechanisms to clarithromycin by GenoType NTM in relation to phenotypic susceptibility testing results_
| No. of strain | Species | GenoType NTM-DR results | Phenotypic results of susceptibility to clarithromycin | |
|---|---|---|---|---|
| Type of bands (WT or mutation) | Molecular mechanisms of resistance (Yes/No) | |||
| 1 | Mabs | erm(41) C28 rrlWT | No | (S) |
| 2 | Mabs | erm(41)T28 rrlWT | Yes | (R) |
| 3 | Mabs | erm(41)T28 rrlWT | Yes | (R) |
| 4 | Mabs | erm(41)T28 rrlWT | Yes | (R) |
| 5 | Mabs | erm(41)T28 rrlWT | Yes | (R) |
| 6 | Mmas | erm(41)T28 rrlWT | Yes | (R) |
| 7 | Mmas | erm(41)T28* rrlWT | No | nt |
| 8 | Mmas | erm(41)T28* rrlWT | No | (S) |
| 9 | Mabs | erm(41)T28 rrlMUT | Yes | (S) |
| 10 | Mb ol | erm(41)T28* rrlWT | No | (S) |
| 11 | Mabs | erm(41)T28 rrlWT | Yes | (R) |
| 12 | Mabs | erm(41)T28 rrlWT | Yes | (R) |